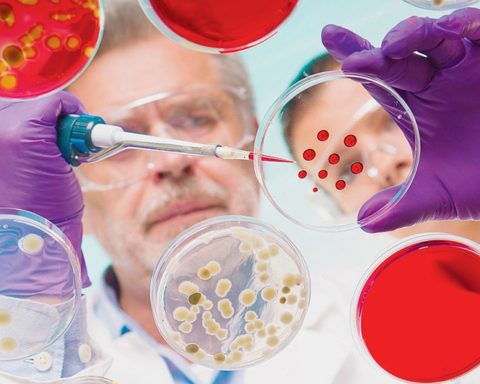

Un rêve de jeunesse éternelle. Voilà la vision d’Altos Labs, cette startup créatrice d’une technologie qui serait capable de rajeunir les cellules et de prétendre à une forme d’immortalité. Elle compte dans son équipe des ténors de la génétique et pas moins de deux prix Nobel. Un rêve à trois
Plus